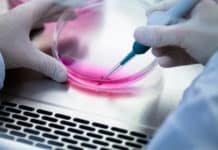
Lab-Grown Bile Ducts Could Slash Liver Transplant Demand PhD Biological Sciences Vacancy @ Novozymes

IUSSTF Studentship / Visiting Fellowships Under Indo-U.S. Genome Engineering / Editing Technology Initiative (GETin)
Acknowledging importance of strategies & techniques in genome modification, as modern day essential tool for research & development, Department of Biotechnology (DBT), Govt. of India along...
EU Approves GM Mosquitoes Meant To Combat Dengue, Chikungunya And Zika
he arboviruses that cause dengue, chikungunya, and Zika illnesses have rapidly expanded across the globe in recent years, with large-scale outbreaks.
In March 2016, the...
Artificial Pancreas in the Making, French Medtech Cellnovo Raises Capital Of €17.5M
The medical technology company Cellnovo, based in Wales, earlier this year had announced the imminent start of a new clinical study for ensuring that...
Biotecnika Times – Newsletter 10.07.2017
25 Positions of Scientists & Technical Assistants @ NCCS,Pune | Salary of Rs. 86,000/-
Applications are invited for the following posts to be filled purely...
Dr. Reddy’s Hiring For Scientist Post in Fermentation Products (Upstream & Downstream Process)
Dr. Reddy's Laboratories Ltd is an integrated global pharmaceutical company, committed to providing affordable and innovative medicines for healthier lives. Through its three businesses...
Lifespan Regulating Genes Identified
“Autophagy has been linked to longevity in many species, but the underlying mechanisms are unclear,” write the scientists in a study (“Spatiotemporal Regulation of...
Celgene Acquires Stake in BeiGene : To help develop cancer Immunotherapy
Celgene wants a shot at a bigger slice of the global cancer drug market, and the company is turning to BeiGene to do it.
On...
Dog Cloned Using Gene Editing – China Becomes Worlds First Country to Do So...
A real life Bolt might now be possible!
Since the cloning of Dolly the sheep in 1997, scientists have moved on to other mammals including...
Oxford BioMedica and Novartis Make a $100m for cell therapy treatment
Oxford BioMedica has revealed today that it has signed a deal potentially worth more than $100m (£77.1m) with Novartis for the supply of material...
Lab-Grown Bile Ducts Could Slash Liver Transplant Demand
Bile is a digestive liquid that is made in the liver. It travels through the bile ducts to the small intestine, where it helps...
This Gene Could Play An Important Role In Depression
We all know how environmental factors or phases of one’s life can influence a person’s mental state; little do we know about the genetics...
Parkinson’s Antibody That Arrests the Disease Starts Phase II of Trials
While standard treatments for Parkinson’s only alleviate symptoms, the Irish pharma Prothena had partnered up with Roche to develop an antibody to hinder the...
Artificial Intelligence And Biotechnology : A Match Made In Healthcare
Artificial Intelligence or AI is fastly becoming an intrinsic and seemingly crucial part of the lifesciences arena.
Today’s biotech industry no longer employs old school...
Wheat Rust : A Fungal Disease Threatening Wheat Crops
An infection that struck wheat crops in Sicily last year has now been deemed a new and unusually devastating strain of fungus, researchers say.
Although...
Eli Lilly and Purdue University Announce Strategic Partnership: Sign a $52M R&D Pact
Eli Lilly and Co. and Purdue University on Thursday announced a strategic five-year agreement—the biggest in Purdue’s history with a biopharma, under which Lilly...